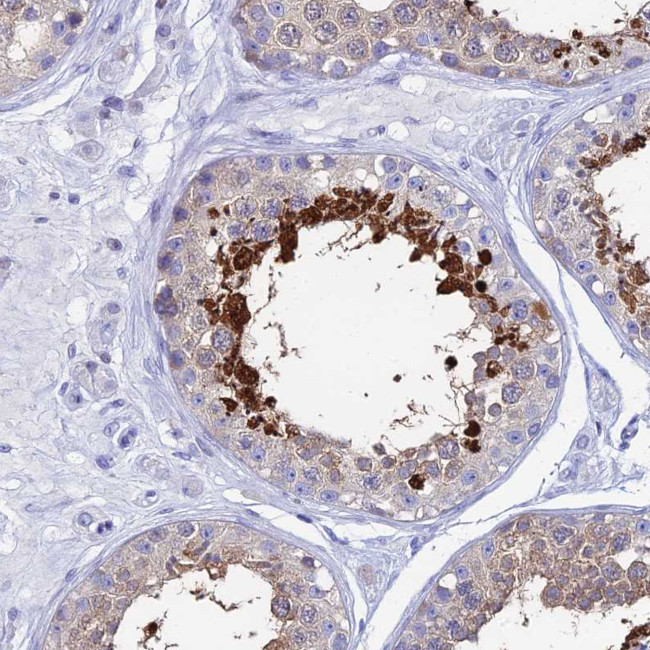
HSP701L Antibody in Immunohistochemistry (Paraffin) (IHC (P))

Search
Invitrogen
HSP701L Polyclonal Antibody
{{$productOrderCtrl.translations['antibody.pdp.commerceCard.promotion.promotions']}}
{{$productOrderCtrl.translations['antibody.pdp.commerceCard.promotion.viewpromo']}}
{{$productOrderCtrl.translations['antibody.pdp.commerceCard.promotion.promocode']}}: {{promo.promoCode}} {{promo.promoTitle}} {{promo.promoDescription}}. {{$productOrderCtrl.translations['antibody.pdp.commerceCard.promotion.learnmore']}}









Please note: We are reviewing Western blot images included in the antibody testing data in our catalog, including those provided by third parties. Unless expressly labeled or annotated as “raw-unedited”, Western blot images included in the antibody testing data in our catalog may have been edited, optimized or otherwise adjusted for presentation.
产品信息
PA5-60310
种属反应
宿主/亚型
分类
类型
抗原
偶联物
形式
浓度
规格
纯化类型
保存液
内含物
保存条件
运输条件
RRID
产品详细信息
Immunogen sequence: KLYQGGCTGP ACGTGYVPGR PATGPTIEEV D
Highest antigen sequence identity to the following orthologs: Mouse - 81%, Rat - 81%.
靶标信息
In response to adverse changes in their environment, cells from many organisms increase the expression of a class of proteins referred to as heat shock proteins. One class of stress proteins, termed the "small heat shock proteins" is comprised of a diverse group of proteins from approximately15 to >30 kDa, with a single form found in yeast and human cells and multiple related forms found in higher plants. A direct relationship between elevated strwess protein expression and neoplasia has been suggested from studies on estrogen-induced proteins in breast cancer cells. In addition, Hsp27 exhibits rapid increased phosphorylation in response to various mitogens, tumor promoter (e. g. phorbol esters) and calcium ionophores. The expression of a 24 kDa protein was shown to correlate with steroid hormone receptor in cell lines, organs, and tumors. The 24 kDa estrogen-induced protein was found to be expressed at high levels in carcinoma of the breast. Another study has suggested that levels of the Hsp27 correlate with endometrial adenocarcinomas. Interestingly, the regulation of human Hsp27 by estrogens and heat shock is reminiscent of the ecdysteroid and heat shock activation of the drosophila Hsp20 genes.
仅用于科研。不用于诊断过程。未经明确授权不得转售。
篇参考文献 (0)
生物信息学
蛋白别名: Heat shock 70 kDa protein 1-Hom; Heat shock 70 kDa protein 1-like; Heat shock 70 kDa protein 1L; Heat shock 70 kDa protein 3; Heat shock 70 kDa-like protein 1; heat shock 70kDa protein 1-like; Heat shock protein; Heat shock protein 70-1l; heat shock protein cognate 70, testis; Heat shock protein family A member 1L; heat shock-related protein hsc70t; HSP70-Hom; HSP70.3; inducible heat shock protein 70; Spermatid-specific heat shock protein 70
基因别名: Hsc70t; Hsp70-3; HSPA1L; Msh5
UniProt ID: (Rat) P55063, (Mouse) P16627
Entrez Gene ID: (Rat) 24963, (Mouse) 15482